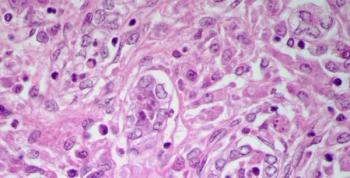

Ahead of the 2015 ASCO Annual Meeting, we are discussing the role of immunotherapy in genitourinary cancers with Susan F. Slovin, MD, PhD.

Your AI-Trained Oncology Knowledge Connection!


Ahead of the 2015 ASCO Annual Meeting, we are discussing the role of immunotherapy in genitourinary cancers with Susan F. Slovin, MD, PhD.

A large majority of prostate tumors sequenced as part of a comprehensive precision medicine study have mutations that can be targeted with available therapies.

Presentation with a urinary tract infection delayed a bladder cancer diagnosis among a population of Medicare patients, with worse delays experienced by women.

At worst radical prostatectomy is equal to radiation therapy in operable very-high-risk prostate cancer, and there are accumulating data to suggest that a surgery-first approach is better induction for multimodal therapy.

It is our opinion that surgery is inappropriate for very-high-risk prostate cancer and that a combination of EBRT and ADT should be the preferred treatment modality.

According to the AREN0532 and AREN0533 trials, adding additional drugs to a therapy regimen for Wilms tumor in children with high-risk disease improved outcomes.

The STAMPEDE trial suggests that survival can be improved in metastatic prostate cancer patients with the addition of docetaxel to frontline hormonal therapy.

Disease progression among prostate cancer patients starting androgen deprivation therapy (ADT) was delayed by 10 months in patients already receiving statins.

Men with metastatic castration-resistant prostate cancer that had mutations in DNA repair genes were more likely to respond to the PARP inhibitor olaparib.
A 62-year-old man presents with anemia and fever. A renal mass is detected and a biopsy is performed. What is your diagnosis?

Too many people are being screened, diagnosed, and treated for certain types of cancer, according to two cancer researchers.

Adding cixutumumab to ADT did not significantly increase the undetectable PSA rate in men with newly diagnosed metastatic hormone-sensitive prostate cancer.

This oncology drug snapshot takes a look at axitinib (Inlyta) for the treatment of advanced renal cell carcinoma (RCC) after failure of one prior systemic therapy.

A combination of biomarkers has shown promise as a surrogate for survival in clinical trials of metastatic castration-resistant prostate cancer.

A new study suggests that men with a history of cardiovascular disease prior to starting ADT are at risk for such events during the first 6 months of treatment.

At this year’s ASCO GU Cancers Symposium, several high-impact and potentially practice-changing abstracts were presented during the prostate cancer session.

A reduction in testosterone levels in the first year of ADT correlates with improved survival in prostate cancer patients being treated for biochemical failure.

Phase II study results found that half of patients with relapsed or refractory urothelial carcinoma responded to treatment with pazopanib and paclitaxel.

In this interview we discuss the changing landscape of systemic therapies for the treatment of bladder cancer.

A 37-year-old man presents with a mass in the left testicle. What is your diagnosis?

As part of our coverage of the ASCO GU Cancers Symposium, we discuss decision-making in the management of patients with early-stage prostate cancer.

The 4Kscore blood test has been shown to accurately detect the presence of high-grade prostate cancer, according to a study presented at ASCO GU.

Two clinical factors may predict PSA response to cabazitaxel in men with metastatic castration-resistant prostate cancer.

Patients with bladder cancer derived an overall survival benefit from the use of adjuvant chemotherapy compared with observation.

Metastatic renal cell carcinoma patients with an elevated neutrophil-to-lymphocyte ratio at baseline had inferior outcomes compared to those with a low ratio.